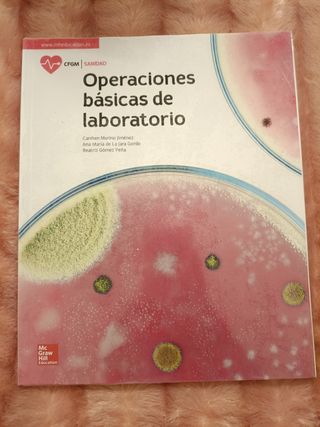

Filtros
Libros Grado Medio de segunda mano Azuqueca de Henares
18 anuncios para ti
Novedades
Encuentra lo que buscas en Wallapop:
También puede interesarte
Libros Grado Medio automoción
Libros Grado Medio Auxiliar farmacia
Libros Grado Medio laboratorio
Libros Grado Medio peluquería
Libros Don Quijote de la Mancha
Libros Disney
Libros Harry Potter
Libros Uned
Libros infantiles
Libros diario de Greg
Libros religiosos
Libros juego de tronos
Libros Thermomix
Libros inglés
Libros Geronimo Stilton
Libros Stephen King